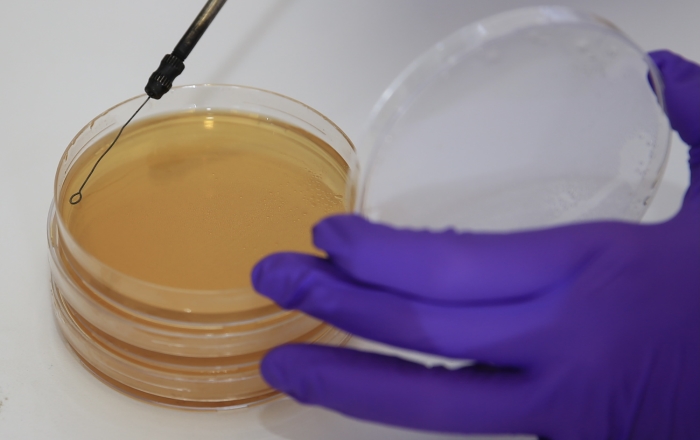

Atıkların değerlendirilmesi konusunda çeşitli çalışmalar yapan SAÜ Gıda Mühendisliği öğretim üyeleri ve öğrencileri, yoğurt altı suyunun değerlendirilmesi konusunda da çalışma başlattı.

TÜBİTAK tarafından da desteklenen projede, üniversitenin laboratuvarında 15 aylık çalışma sonucunda yoğurt suyuyla limon ve sirkeyle yapılan turşunun lezzetinin yakalandığı tespit edildi.

Proje yürütücüsü SAÜ Gıda Mühendisliği Doktor Öğretim Üyesi Mustafa Öztürk, AA muhabirine, sürdürülebilir bir dünya ve çevre için endüstriyel yan ürünlerin geri kazanılması, bunlara ekonomik değer atfedilmesinin önemli olduğunu söyledi.

Süzme yoğurt üretiminde ortaya çıkan atık suyun değerlendirilmesi üzerine çalışmalar yürüttüklerini ifade eden Öztürk, "Sadece Amerika'da yıllık 1,5 milyon tonluk süzme yoğurt atık suyu ortaya çıkıyor. Bunun için uygun bir kullanım alanı bulunamadı." dedi.
Yoğurt suyunun peynir altı suyu gibi işlenemediğini dile getiren Öztürk, "İşlenme sırasında önemli problemler meydana çıkıyor, kurutma aşamasında problemler ortaya çıkıyor. Amerika'nın New York eyaletinde doğaya salındığı zamanlar asit değerinin yüksek olmasından dolayı toprağın asitliğini artırdığını, yer altı sularının yapısını bozduğunu, göllerde balık ölümlerine yol açtığına dair pek çok çalışma zaten biliniyor. Son 10 yılda da dünyada bu konuda bir çalışma var." ifadelerini kullandı.

Yaptıkları çalışmayla Türk sinemasına da konu olan "turşu limonla mı sirkeyle mi yapılır" tartışmasına yeni bir boyut kazandırdıklarını belirten Öztürk, "Bildiğiniz gibi Türk sinemasında da bir tartışma vardı, rahmetli Münir Özkul ve Adile Naşit'in. Daha iyi turşu sirkeden mi olur yoksa limondan mı olur diye. Biz 'yoğurt altı suyundan da olabilir' diyoruz. Tabii ki takdir yapanların ve deneyenlerindir. Zevkler ve renkler tartışılmaz." dedi.

Öztürk, bu alandaki çalışmalarını tamamladıklarını, sonuç olarak hem görsel hem de lezzet olarak süzme yoğurt suyu ile yapılan turşuların, sirkeyle yapılanlardan farkı olmadığını gördüklerini anlattı.


Proje danışmanı Gıda Mühendisliği Öğretim Üyesi Prof. Dr. Arzu Çağrı Mehmetoğlu da yoğurt suyunun çevreye verdiği zararın önüne geçmek amacıyla bir kullanım alanı oluşturulduğunu anlattı.

Yoğurt suyunun sirkeye alternatif olarak turşuda kullanıldığını ve güzel sonuçlar alındığını bildiren Mehmetoğlu, şunları kaydetti:

"Turşu çok önemli bir probiyotik kaynağıdır. Bu yoğurt altı suyuyla turşunun probiyotik kaynağı da arttı. Normal klasik turşuya göre bu turşu tüketildiğinde hem sağlık açısından faydalı olacak hem de endüstride daha ekonomik bir ürün elde edilecek çünkü atıktan elde edilen bir üründür bu. Ekonomik açıdan daha maliyeti düşük ürün elde edeceksiniz.

Bundan sonraki çalışmalarımızda da elde ettiğimiz bu turşulardaki probiyotiklerin analizleri yapılacak ve TÜBİTAK'a proje olarak sunulacak."

Doktora öğrencisi Özlem Öztürk Çetin de TÜBİTAK tarafından desteklenen bir projede çalışma fırsatı bulduğunu, 15 aylık çalışmanın tamamlandığını aktardı.

Dünya üzerinde yoğurt altı sularının değerlendirilebilirliği hakkında çalışmaların devam ettiğini söyleyen Çetin, "Biz de aslında bir atık olarak değerlendirilen başka bir gıdadan ham madde olarak kullanılabilirliğini kanıtlamış olduk. Turşuyu yaptık, artık limondan değil sirkeden değil yoğurt altı suyundan yapmalarını bekliyoruz." dedi.